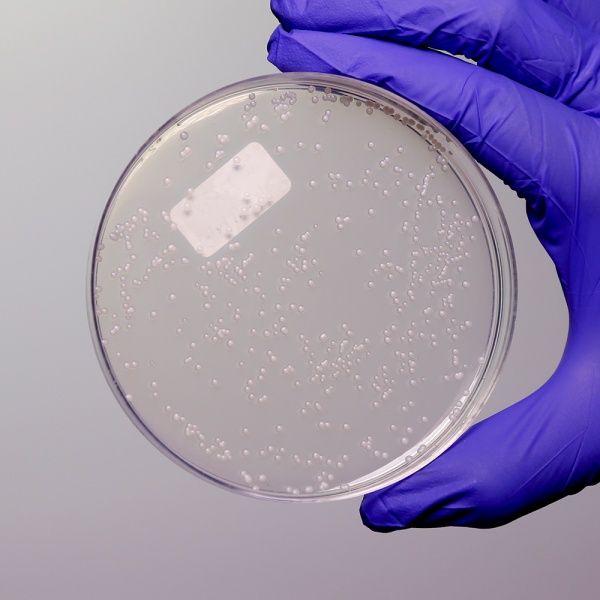

Shop Products 
Please login to your online account to display your discounted pricing
Catalog No: CG-GM1064-500G
On Request
Catalog No: CG-GM108-500G
On Request
Catalog No: CG-GM1083-500G
On Request
Catalog No: CG-GM1090-500G
On Request
Catalog No: CG-GM1091-500G
On Request
Catalog No: CG-GM112A
On Request
Catalog No: CG-GM1137-500G
On Request

Filter
Filter